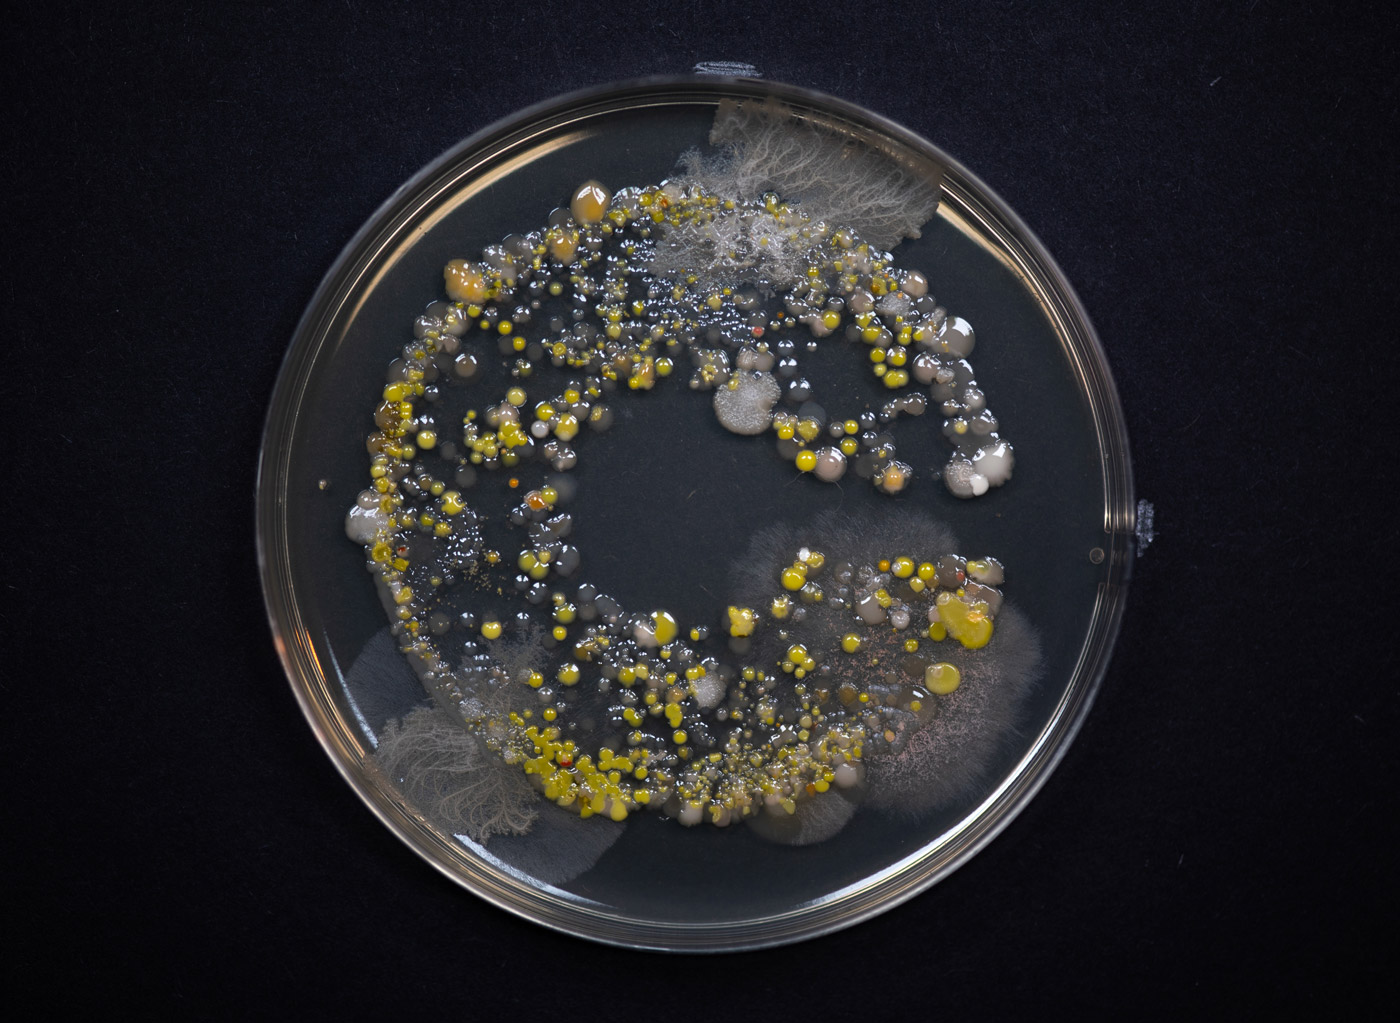

While working at Madalena Studio I was part of the Crucible rebrand project with the main focus on the new website.
Crucible is a laboratory, collaborative workspace and creative hub for bartenders, brands and entrepreneurs, as well as
a world class, innovation-led drinks consultancy.
For this project we wanted to create something that would mirror the process of the creative work Crucible does.
The idea was to create something impactful, we wanted
to engage with the audience, but also reflect the brand in
the most authentic and precise way.
Crucible is a laboratory, collaborative workspace and creative hub for bartenders, brands and entrepreneurs, as well as
a world class, innovation-led drinks consultancy.
For this project we wanted to create something that would mirror the process of the creative work Crucible does.
The idea was to create something impactful, we wanted
to engage with the audience, but also reflect the brand in
the most authentic and precise way.
Digital content
rebranding
website design
rebranding
website design

Featured on It’s Nice That and Creative Review.